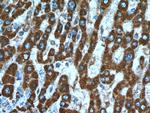
SHH Antibody in Immunohistochemistry (Paraffin) (IHC (P))
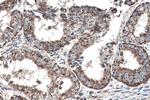
SHH Antibody in Immunohistochemistry (Paraffin) (IHC (P))

Search
Proteintech
SHH Polyclonal Antibody
{{$productOrderCtrl.translations['antibody.pdp.commerceCard.promotion.promotions']}}
{{$productOrderCtrl.translations['antibody.pdp.commerceCard.promotion.viewpromo']}}
{{$productOrderCtrl.translations['antibody.pdp.commerceCard.promotion.promocode']}}: {{promo.promoCode}} {{promo.promoTitle}} {{promo.promoDescription}}. {{$productOrderCtrl.translations['antibody.pdp.commerceCard.promotion.learnmore']}}
图: 1 / 20
SHH Antibody (20697-1-AP) in ICC/IF

产品信息
20697-1-AP
种属反应
已发表种属
宿主/亚型
分类
类型
抗原
偶联物
形式
浓度
规格
纯化类型
保存液
内含物
保存条件
运输条件
靶标信息
Sonic Hedgehog (SHH), which is expressed only during embryogenesis, is instrumental in patterning the early embryo. It has been implicated as the key inductive signal in patterning of the ventral neural tube, the anterior-posterior limb axis, and the ventral somites. Of three human proteins showing sequence and functional similarity to the Sonic Hedgehog protein of Drosophila, this protein is the most similar. The protein is made as a precursor that is autocatalytically cleaved, the N-terminal portion is soluble and contains the signalling activity while the C-terminal portion is involved in precursor processing. More importantly, the C-terminal product covalently attaches a cholesterol moiety to the N-terminal product, restricting the N-terminal product to the cell surface and preventing it from freely diffusing throughout the developing embryo. Defects in this protein or in its signalling pathway are a cause of holoprosencephaly (HPE), a disorder in which the developing forebrain fails to correctly separate into right and left hemispheres. HPE is manifested by facial deformities. In addition, it is thought that mutations in this gene or in its signalling pathway may be responsible for VACTERL syndrome, which is characterized by vertebral defects, anal atresia, tracheoesophageal fistula with esophageal atresia, radial and renal dysplasia, cardiac anomalies, and limb abnormalities.
仅用于科研。不用于诊断过程。未经明确授权不得转售。
生物信息学
蛋白别名: hemimelic extra toes; HHG-1; SHH; Shh unprocessed N-terminal signaling and C-terminal autoprocessing domains; ShhNC; short digits; sonic hedgehog homolog; Sonic hedgehog protein
基因别名: 9530036O11Rik; Dsh; HHG1; HLP3; HPE3; Hx; Hxl3; M100081; MCOPCB5; SHH; ShhNC; SMMCI; TPT; TPTPS; Vhh-1
UniProt ID: (Human) Q15465, (Mouse) Q62226, (Rat) Q63673
Entrez Gene ID: (Human) 6469, (Mouse) 20423, (Rat) 29499



